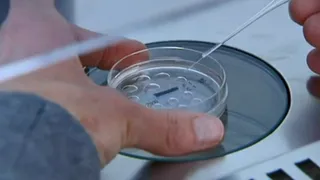

een zoektocht naar de toekomst van onze soort

Een baby gemaakt uit drie ouders, met één pil een traumatische herinnering wissen, met laserlicht iemands gedrag sturen of menselijke organen opkweken in varkens. Geen sciencefiction, maar realiteit. In de zesdelige Human/VPRO serie De Volmaakte Mens (2015) gaat schrijver en columnist Bas Heijne op zoek naar de toekomst van onze soort.
Wat is de mens?
Wereldwijd werken wetenschappers aan nieuwe technieken die onze ongemakken wegnemen, gebreken repareren en ons gezonder, slimmer, handiger en ouder maken. Maar wat gebeurt er met ons mens-zijn als ingrijpende technieken net zo vanzelfsprekend worden als een kunstgebit of steunkous? En als verbeteren net zo gewoon wordt als genezen? Hoe beïnvloedt dit onze samenleving?
In zes afleveringen trekt Bas Heijne langs laboratoria over de hele wereld, waar wetenschappers hem hun baanbrekende vindingen tonen. Met filosofen en andere denkers buigt Heijne zich over de ethische dilemma’s die deze ontwikkelingen met zich meebrengen. Wat zijn de maatschappelijke gevolgen als perfectie de norm wordt en imperfectie een keuze? Wie is verantwoordelijk voor de gevolgen van technologische ontwikkelingen? En worden we er meer of minder mens van?
De Volmaakte Mens is veel meer dan alleen een televisieserie. Ook andere programma’s op radio en televisie, zoals Andere Tijden, OVT, VPRO Tegenlicht en OBA-live besteden aandacht aan het thema. In aansluiting op De Volmaakte Mens zendt NPO Doc tussen 9 en 15 mei 2015 documentaires over nieuwe technieken die het mogelijk maken om in te grijpen in de menselijke natuur en over de ethiek hiervan. Het NRC zal stukken publiceren van presentator Bas Heijne.
Op deze website verschijnen regelmatig interessante relevante artikelen.
Via Facebook en Twitter blijf je op de hoogte van de laatste ontwikkelingen van De Volmaakte Mens. Daar is ook alle ruimte om jouw stem te laten horen, met de hashtag #dvm. Naast online platformen kun je ook terecht bij de afdeling Studium Generale van diverse universiteiten en hogescholen voor lezingen en debat.
De volmaakte mens
Human en VPRO's wetenschapsprogramma van 2015: over technologie en ethiek. Wat mag de wetenschap ons allemaal brengen en waar moeten we stoppen?
contact
De redactie van De Volmaakte Mens is te bereiken via e-mail: devolmaaktemens@vpro.nl.

Human is een van de zeven levensbeschouwelijke omroepen zonder leden. Human is de enige niet-religieuze en vertegenwoordigt het humanisme in Nederland.

De VPRO is een publieke omroep waarbinnen creativiteit, wereldburgerschap, innovatie en eigenzinnigheid leidraad zijn, met het publiek als uitgangspunt. Voor dat publiek, de creatieve klasse, wil de VPRO een knooppunt zijn van vakmanschap en expertise, betrokkenheid en passie.
meer over dit onderwerp? bekijk deze leestips
- VPRO Tegenlicht: Ik en het web
- Studium Generale: Over de nieuwe mens
- Rathenau Instituut: Publicatie 'Goed, beter, betwist'
- Rathenau Instituut: De Supermenstest
- Rathenau Instituut: Intieme technologie
- De Maakbare Mens: Belgische non-profitorganisatie over bio-ethiek
- De Volkskrant: Wetenschap en de maatschappij